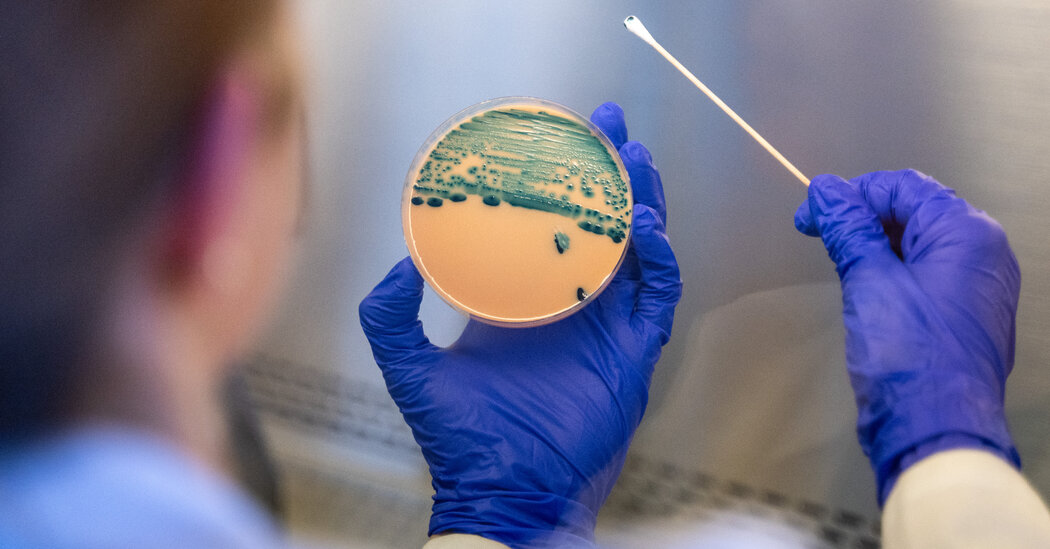
A Widespread Stomach Virus Is Now More Difficult to Manage

Rising Infections from Drug-Resistant Shigella
Infections from drug-resistant shigella, a bacteria known to cause diarrhea, have reportedly increased recently, according to a warning from the Centers for Disease Control and Prevention.
These particular strains, referred to as extensively drug-resistant (XDR), show no response to the five antibiotics that had traditionally been effective for treating severe cases.
To put things in perspective, in 2011, the United States recorded no drug-resistant shigella infections; however, by 2023, XDR strains represented 8.5 percent of all shigella infections. It’s noteworthy that these XDR strains were first spotted in the U.S. a decade ago.
Dr. Judith O’Donnell, who leads the infectious diseases division at Penn Presbyterian Medical Center, remarked, “Historically, treating this infection was relatively simple for the few people who needed antibiotics. But now, we’re witnessing a significant change, or perhaps an evolution, in the bacterial resistance genes.”
Nevertheless, experts in infectious diseases and epidemiology urge people to remain grounded because fewer than 10 percent of cases are actually drug-resistant. The C.D.C. estimates that shigella is responsible for about 450,000 infections annually in the U.S.
Dr. Patrick Kenney, a clinical assistant professor of pediatrics at the University at Buffalo, stated, “It is indeed alarming that extensively drug-resistant shigella cases are escalating so rapidly. But most individuals will recover independently.”
Understanding Shigella
The bacteria lead to an infection known as shigellosis, which is generally mild and resolves without antibiotics over the course of a week or so, mainly with rest and hydration. The primary symptom is diarrhea.
However, some individuals may endure symptoms that are quite debilitating, explained Dr. Wilbur Chen, an infectious disease physician and scientist at the University of Maryland School of Medicine. Symptoms can include bloody stools, prolonged diarrhea lasting more than three days, and severe abdominal cramps. In such cases, an antibiotic might be necessary.
Dr. Chen also pointed out that it doesn’t take many bacteria to transmit shigella, making it easily spread from one person to another.
While anyone can become infected, children under 5 years old are particularly at risk—typical for bacteria that spread through the fecal-oral route. For instance, if an infected child neglects to wash their hands after using the bathroom, they might pass the bacteria to a friend through a shared toy or door handle.
People can also contract the infection by consuming food prepared by an infected individual or by swallowing contaminated water while swimming.
The recent C.D.C. report highlighted that most drug-resistant shigella infections occurred among adult men. Although the report didn’t delve into sexual exposure data, past research has indicated that outbreaks can happen among men who have sex with men.
Dr. O’Donnell remarked, “There’s likely a considerable amount of sexual transmission taking place, emphasizing the importance of safer sex practices. Awareness among patients is crucial.”
Experts recommend frequent hand washing and avoiding swallowing water from lakes or pools as some of the most effective preventive measures against infection.
Looking Forward
Shigella isn’t the only bacteria showing increased antibiotic resistance.
A report from the World Health Organization indicated that global antimicrobial resistance—where bacteria, viruses, fungi, or parasites resist treatment—is rising by as much as 15 percent annually.
Dr. Geeta Sood, an assistant professor of medicine and hospital epidemiologist at Johns Hopkins Bayview Medical Center, noted that overusing antibiotics significantly contributes to this resistance.
Antimicrobial resistance is a natural process that develops over time as microbes evolve to survive against medications aimed at eradicating them. However, unnecessary use or misuse can speed up this resistance, allowing germs to mutate and transfer their resilience to others, making resistant infections much tougher to treat.
Dr. Chen highlighted that because drug-resistant shigella cannot be managed with standard oral antibiotics, patients often require stronger intravenous treatments in a hospital setting, with nearly 40 percent of cases reported leading to hospitalization. Although there are oral and intravenous options for these patients, an ideal therapy hasn’t yet been determined.
The new report only analyzed data up until 2023, as it takes time for federal data collection and analysis. Experts are hesitant to predict whether drug-resistant infections have worsened since then but aren’t optimistic.
Dr. Sood expressed concern, saying, “The trend for nearly all of these infections is an increase in resistance rates. If I were to make a prediction, I’d say we could expect to see rising cases of XDR shigella.”